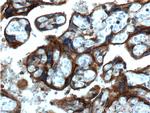
Annexin IV Antibody in Immunohistochemistry (Paraffin) (IHC (P))

Search
Proteintech
Annexin IV Monoclonal Antibody (1A10B5)
{{$productOrderCtrl.translations['antibody.pdp.commerceCard.promotion.promotions']}}
{{$productOrderCtrl.translations['antibody.pdp.commerceCard.promotion.viewpromo']}}
{{$productOrderCtrl.translations['antibody.pdp.commerceCard.promotion.promocode']}}: {{promo.promoCode}} {{promo.promoTitle}} {{promo.promoDescription}}. {{$productOrderCtrl.translations['antibody.pdp.commerceCard.promotion.learnmore']}}
产品信息
60288-2-IG
种属反应
宿主/亚型
分类
类型
克隆号
抗原
偶联物
形式
浓度
纯化类型
保存液
内含物
保存条件
运输条件
产品详细信息
Immunogen sequence: GTDEDAIIS VLAYRNTAQR QEIRTAYKST IGRDLIDDLK SELSGNFEQV IVGMMTPTVL YDVQELRRAM KGAGTDEGCL IEILASRTPE EIRRISQTYQ QQYGRSLEDD IRSDTSFMFQ RVLVSLSAGG RDEGNYLDDA LVRQDAQDLY EAGEKKWGTD EVKFLTVLCS R (33-202 aa encoded by BC000182)
靶标信息
Annexin IV (ANX4) belongs to the annexin family of calcium-dependent phospholipid binding proteins. Although their functions are still not clearly defined, several members of the annexin family have been implicated in membrane-related events along exocytotic and endocytotic pathways. ANX4 has 45 to 59% identity with other members of its family and shares a similar size and exon-intron organization. Isolated from human placenta, ANX4 encodes a protein that has possible interactions with ATP, and has in vitro anticoagulant activity and also inhibits phospholipase A2 activity. ANX4 is almost exclusively expressed in epithelial cells.
仅用于科研。不用于诊断过程。未经明确授权不得转售。
篇参考文献 (0)
生物信息学
蛋白别名: 35-beta calcimedin; Annexin A4; Annexin IV; annexin IV (placental anticoagulant protein II); Annexin-4; ANXA 4; Carbohydrate-binding protein p33/p41; Chromobindin-4; Endonexin I; epididymis secretory protein Li 274; Lipocortin IV; P32.5; PAP-II; Placental anticoagulant protein II; PP4-X; proliferation-inducing gene 28; proliferation-inducing protein 28; Protein II
基因别名: ANX4; ANXA4; HEL-S-274; P32.5; PAP-II; PIG28; PP4-X; ZAP36
UniProt ID: (Human) P09525
Entrez Gene ID: (Human) 307